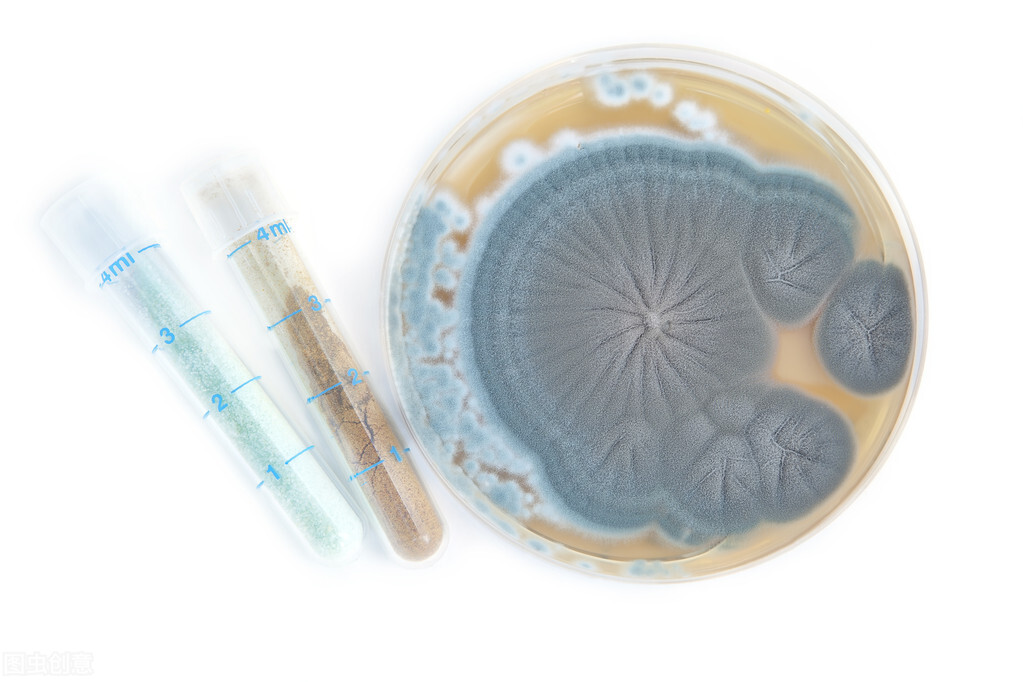
伟哥、可口可乐、青霉素，起底“宇宙第一大药厂”的发家史

“开售当年,全球超过20万名医生,为300万名患者,开出了超过700万条处方,涉及超过5000万片“伟哥”产品。”
辉瑞制药是什么企业?
是“伟哥”万艾可的创造者,是可口可乐背后的功臣,而且还是诺曼底登陆战的“超级后援”。
在21世纪的前20年里,在制药界被称为“宇宙第一大药厂”的辉瑞制药,一直稳坐世界药企销量冠军的宝座。
直到2020年,它才第一次跌落神坛。
这篇文章,扒一扒辉瑞的发家史。

你可能不知道辉瑞,但一定知道万艾可、青霉素。
1919年,可口可乐供应商,第一次发战争财
1919年,由于第一次世界大战爆发,刚上市不久的可口可乐,从每股股价40美元跌到了19.5美元。
原因是海上货运中断,欧洲的柠檬和酸柠运到美国时价格要翻上好几倍。这导致可口可乐最关键的原料——柠檬酸断货了。
要知道,可口可乐的原料表非常简单:水、糖、咖啡因、柠檬酸。
参考2020年老干妈辣酱换配方上热搜的事件,我们不难想到:如果当时可口可乐采用其它原料替代柠檬酸,则消费者很容易发觉口味的改变,可能对可口可乐品牌造成极大的伤害。
因此拯救可口可乐的重任就落到了柠檬酸供应商——辉瑞的身上。

可口可乐
在当时,辉瑞的一名化学家詹姆斯·柯里发现,用黑曲霉素和糖可以生成柠檬酸。
基于此发现,柠檬酸的价格一路下跌,辉瑞也成了第一次世界大战中可口可乐的大功臣。
作为回报,整个一战期间可口可乐的柠檬酸几乎都是辉瑞提供的,辉瑞的产品也随着可口可乐被送往世界各地。
此时的辉瑞,尚且不能算作一家药企。而这个重要的转折,发生在二战的时候。

一战留下的老式飞机,随之留下的还有新的机遇。
1944年,英国政府*用军**青霉素,辉瑞的第二次战争财
青霉素被誉为20世纪最伟大的发明之一,由英国科学家弗莱明在1928年发现,但却一直得不到重视,原因是提纯非常困难,无法量产。
直到第二次世界大战,英国*队军**伤亡惨重,向美国寻求合作,探索生产青霉素的方法。
美国政府也很干脆,直接把这件事接洽给了一战后一直用黑曲霉素生产柠檬酸的辉瑞。
鉴于长期与黑曲霉素打交道的经验,辉瑞用了不到3年时间就突破了技术阻碍。1944年,一天的产量就能超过之前一年的产量。
青霉真菌
成功量产青霉素后的辉瑞,马上又凭借量产青霉素的经验,研发出了土霉素药。
至此,辉瑞从一家给可乐制造柠檬酸的化工厂,摇身蜕变成一家正儿八经的药企。
二战期间,辉瑞依靠独特的发酵技术,生产了全世界近一半的青霉素。在著名的诺曼底登陆战争中,超过90%的盟军都是携带辉瑞生产的青霉素,可谓是“超级后援”。
青霉素和土霉素药品在后来的十几年里,为辉瑞带来了超过5亿美元的收入。

诺曼底登陆旧址
1998年,蓝色小药丸上市,“伟哥”风靡全球
“伟哥”万艾可的发明有一点点传奇色彩。
从1985年开始,辉瑞的研发团队开始着手研究一种能够扩张血管、抗凝血的药物。原本这种药物是被寄希望于抗高血压的,但是如果你是一个理科生,你也很容易猜到:具备这样功能的药物,很可能也会具有“伟哥”的效果。
经过5年的辛苦研发,测试了超过1500种成分的辉瑞团队,最终发现了枸橼酸西地那非。在实验中,这种药物可以很好地扩张血管。
然而这种承载着辉瑞上下巨大期望的药物,却在临床试验中取得了巨大的失败:枸橼酸西地那非并没有明显的抗高血压、抗凝效果。
就在科学家心已经凉了一半时,却意外地发现,这种药有另一个神奇的功能——治疗“男性勃起功能障碍”。

万艾可的“蓝色小药丸”形象曾称霸线下药店
经过研发团队激烈的讨论后,大家一致决定:“尽管作为一个抗高血压的药物,枸橼酸西地那非彻底地失败了。但是作为一款治疗男性勃起功能障碍的药物,值得继续研发下去。”
于是,1998年,蓝色小药丸“万艾可”正式上市售卖。
开售当年,全球超过20万名医生,为300万名患者,开出了超过700万条处方,涉及超过5000万片“伟哥”产品。
此药直接奠定了接下来20年,辉瑞制药在世界制药界的龙头地位。也为后来辉瑞的疯狂并购,提供了充足的资金。

万艾可的成功,既成就了辉瑞,也为很多家庭带来了幸福。
2000年,新的世纪开启,辉瑞也开始了疯狂并购其它药企的路程。
至此,辉瑞发家的历史可谓告一段落。
你对辉瑞的三段式发家史有什么看法呢?
至于后来并购的路走得怎么样?以及辉瑞是如何最终成为“宇宙第一大药厂”,并且创造“辉瑞模式”的?甚至为何会被第二、三名药企反超?
这些问题,留给我们以后的文章去探讨吧~
看商业发展,品智慧生活,关注期颐人生!